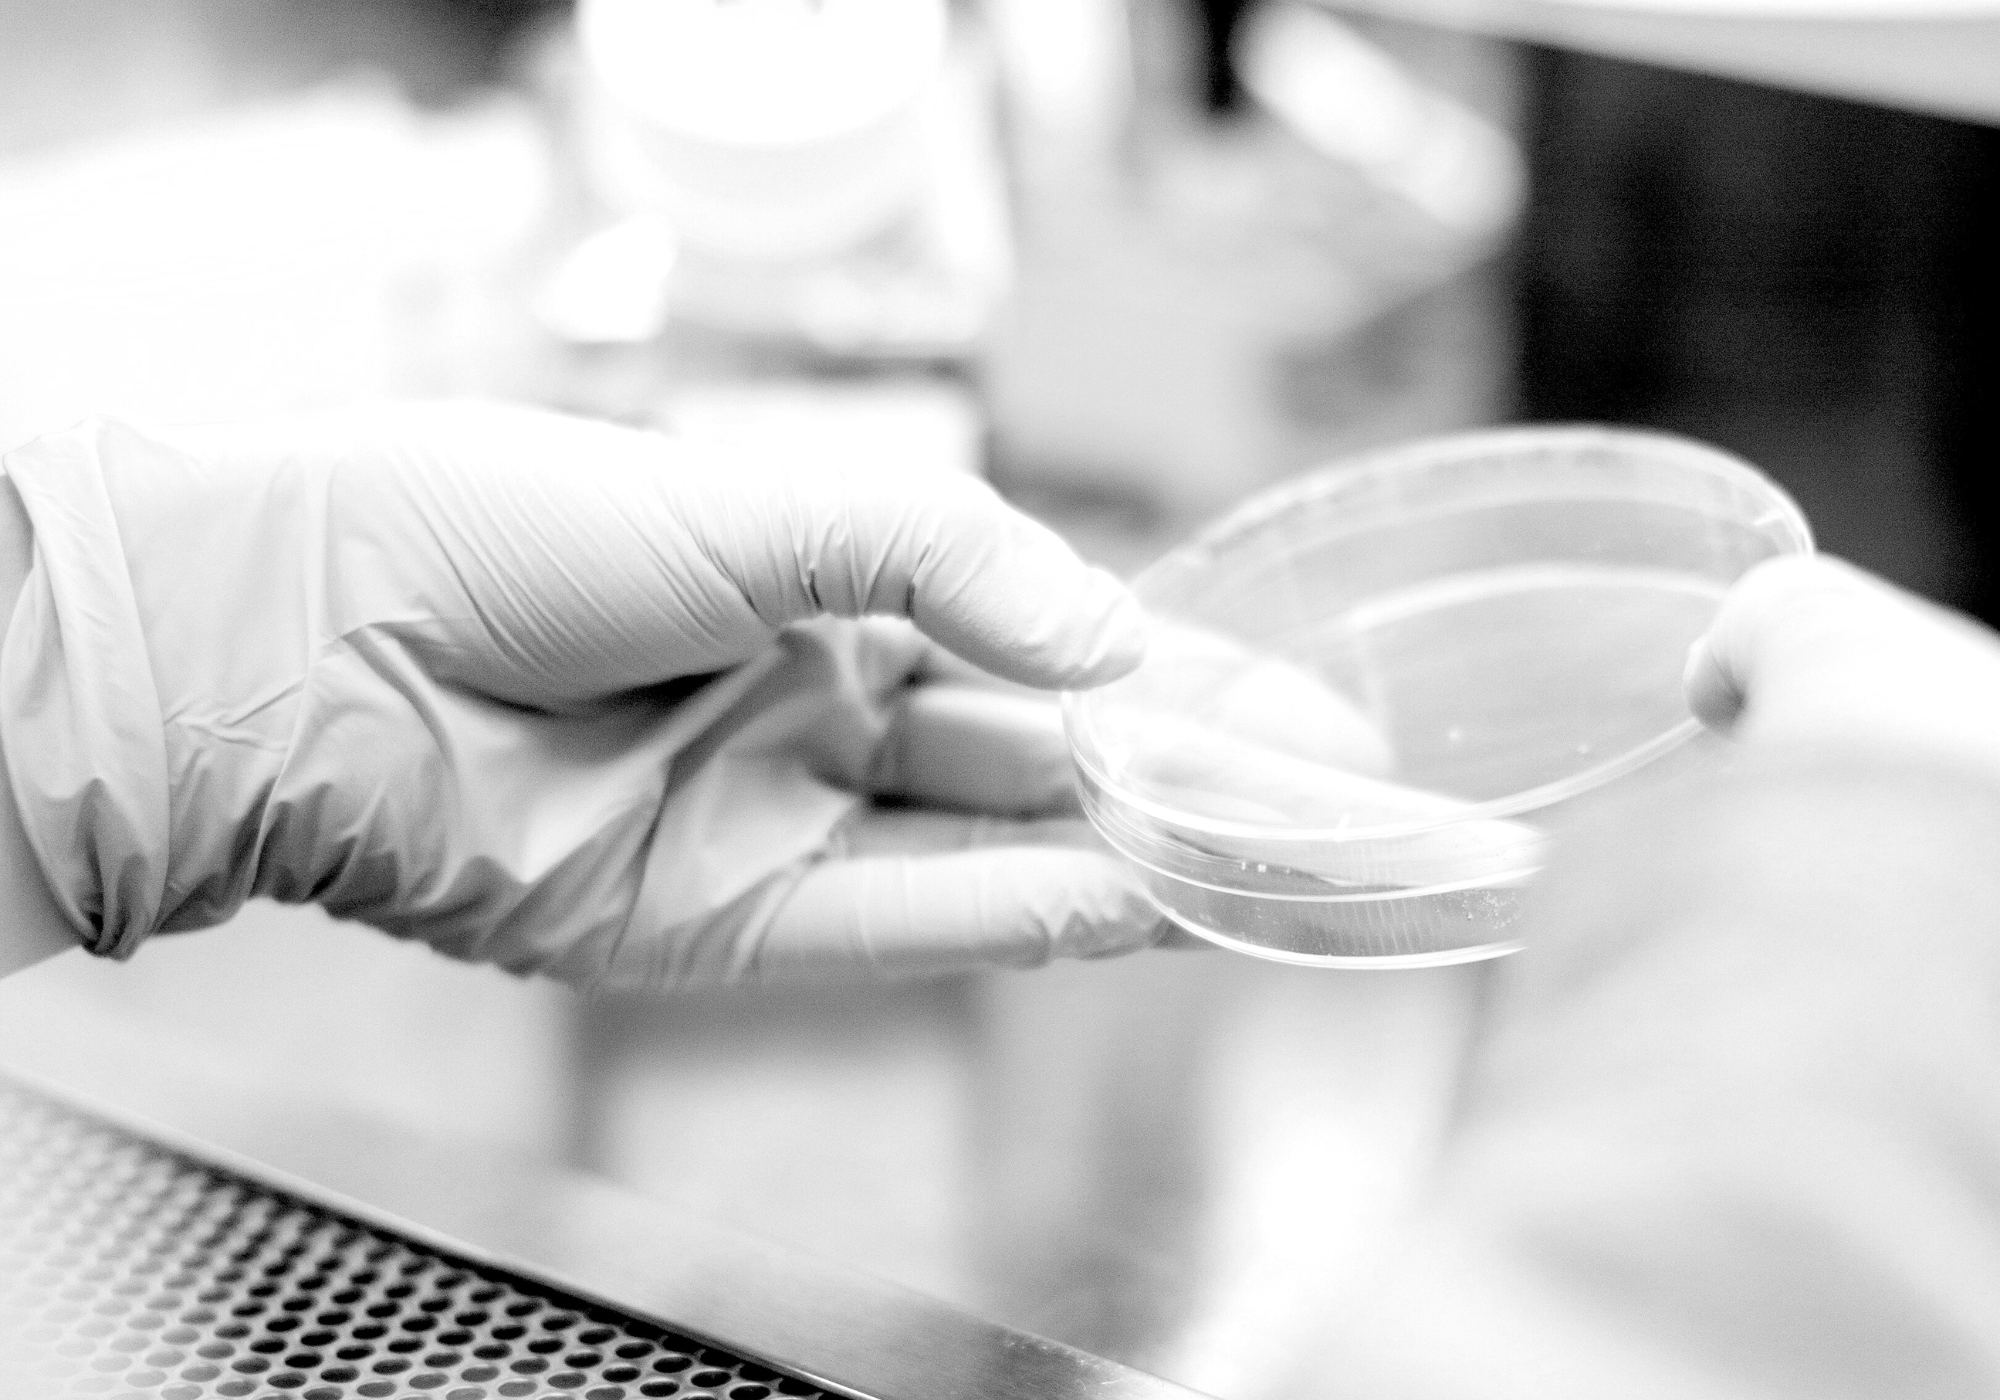

Vi gjør recovery smartere
Drevet av vitenskap, støttet av ekte utøvere og utviklet for dem som stiller høyere krav til både kroppen sin og ernæringen sin.
Hos Smartfish kombinerer vi norsk oppfinnsomhet med forskning i verdensklasse for å skape restitusjon du faktisk kan kjenne. Ingen snarveier, ingen gimmicker - bare ren ytelse i hver slurk.
Siden 2001

OPPHAV
Smartfish som en sportsdrikk ble skapt i 2006. Siden da har vi vært en del av recovery-rutinen til eliteutøvere over hele verden.

Verdensklasse
Oppdraget vårt er enkelt; å lage den beste recoverydrikken i verden, og å tilby den til alle atleter som vil prestere bedre, uansett nivå.
Kvalitet
Smartfish er et rent produkt laget av enkle, validerte ingredienser. Ingen kunstig søtning, ingen konservering, ingen unødvendige tilsetningsstoffer.
Møt teamet vårt
Høyt kvalifiserte mennesker som brenner for bedre restitusjon.









En fruktig proteindrikk beriket med norsk omega-3 fra bærekraftige kilder.